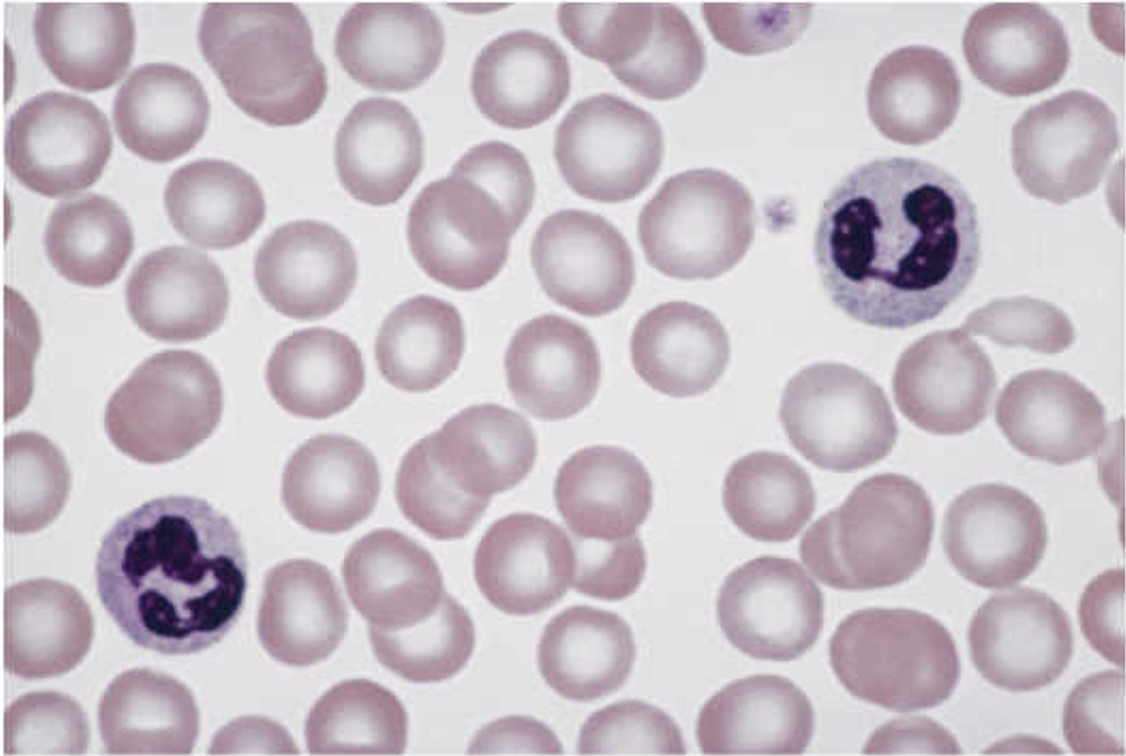
<p></p><p>Tiny Circle</p>
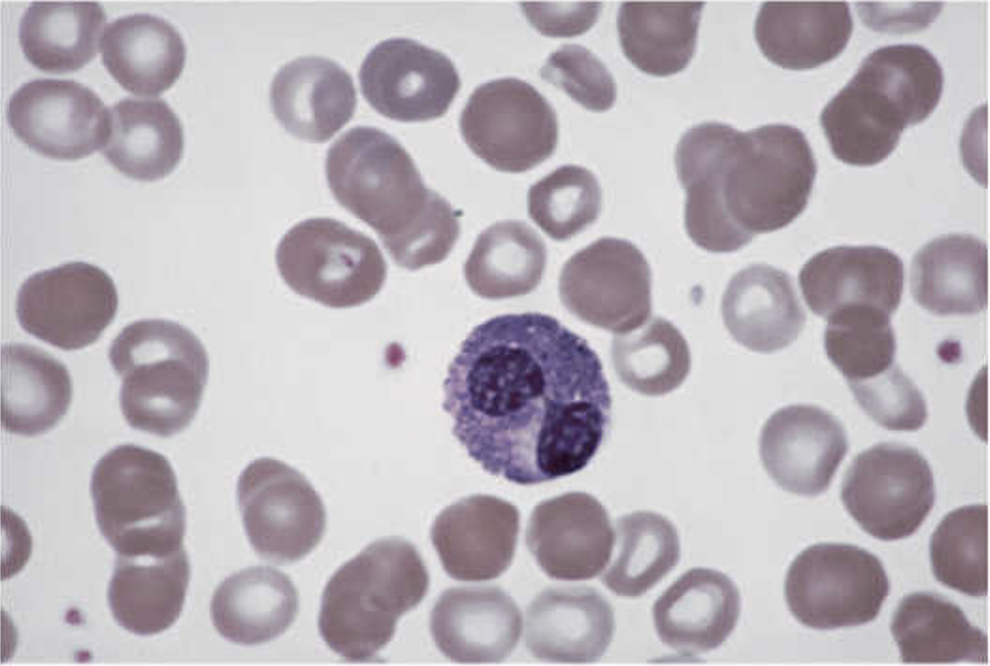
term image
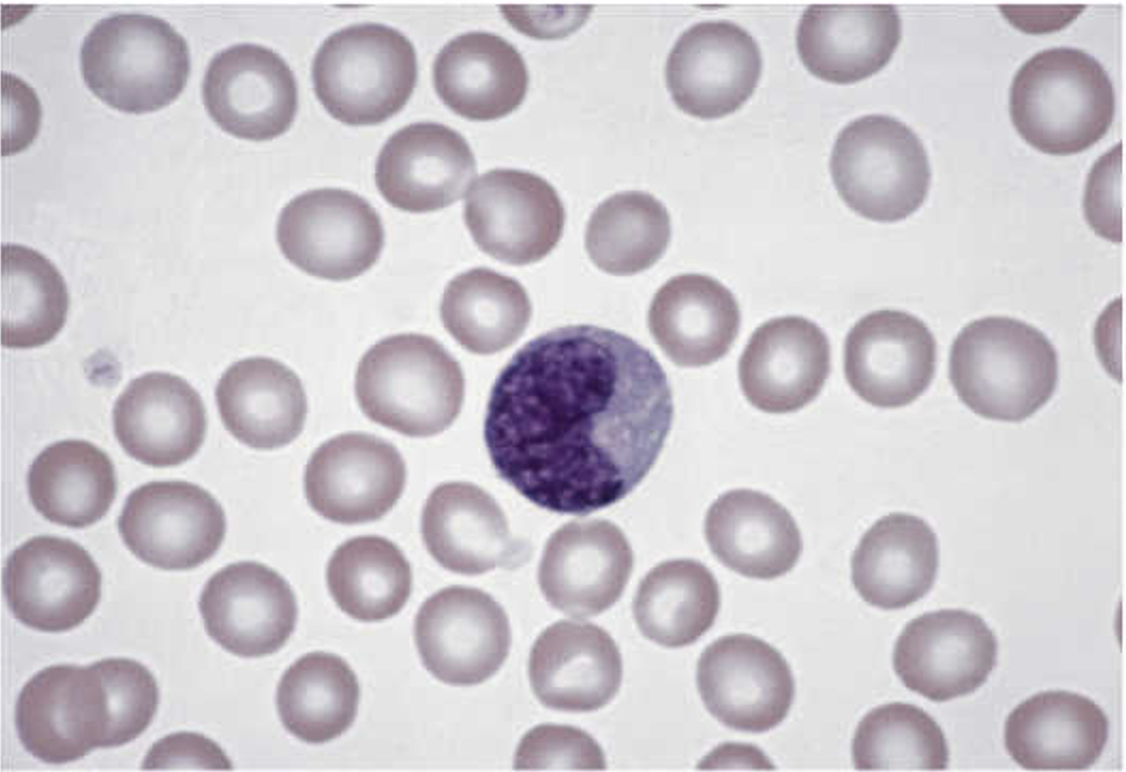
term image
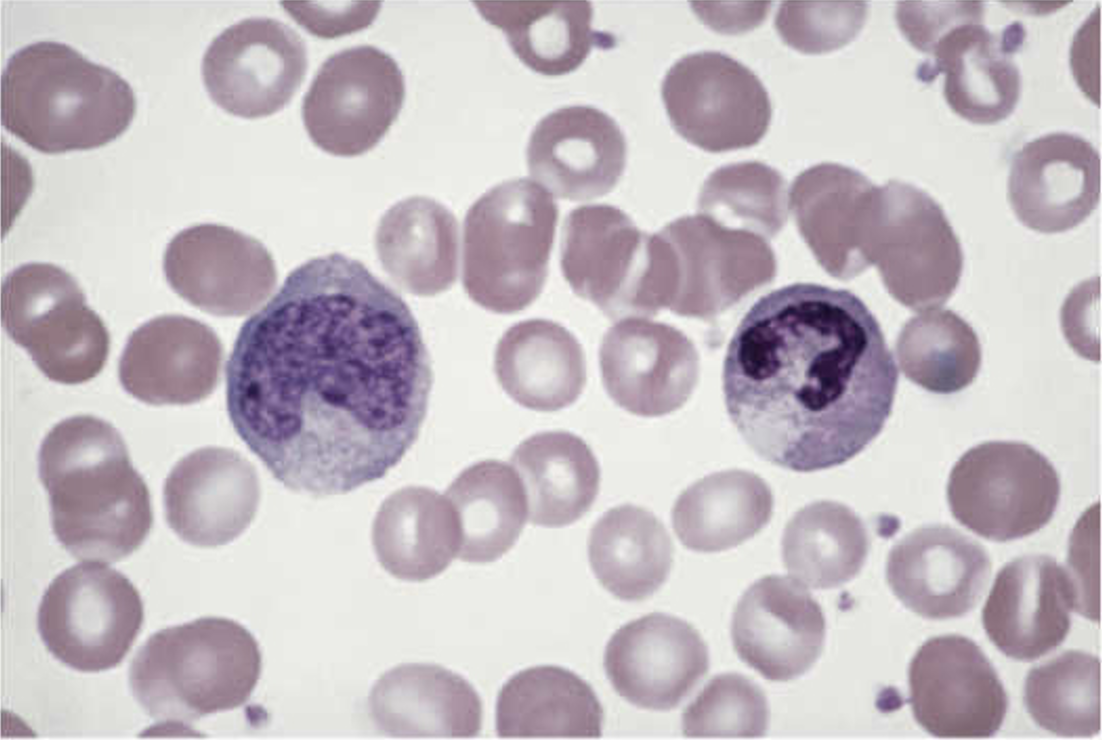
<p>Circle on right</p>
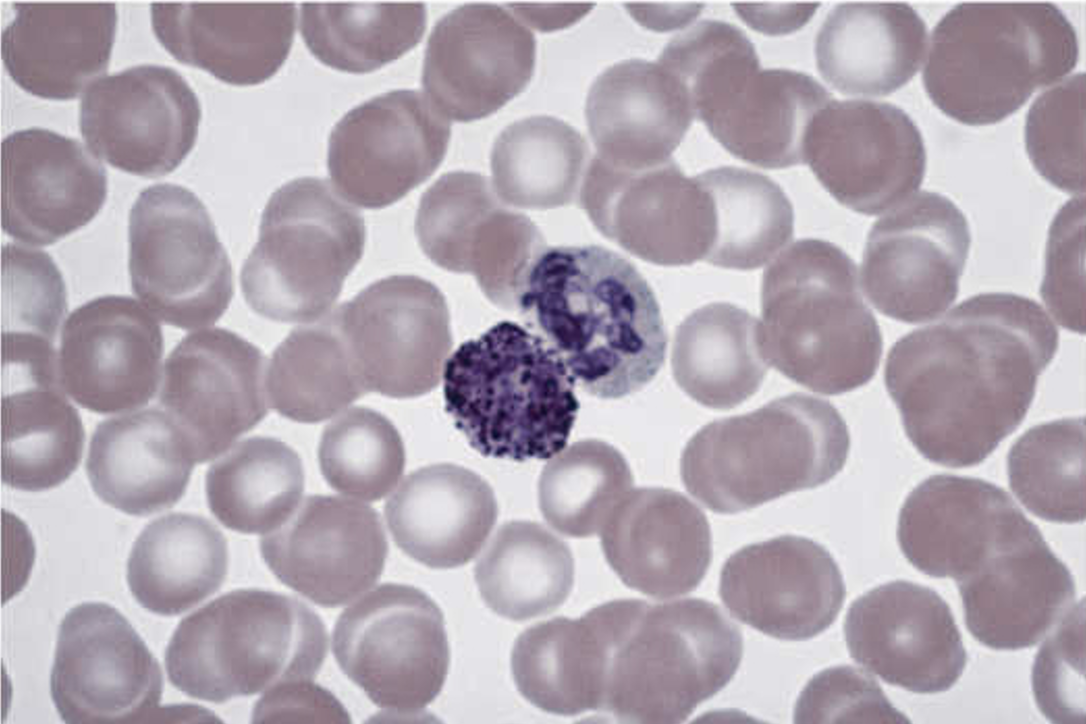
<p>Circle on left</p>
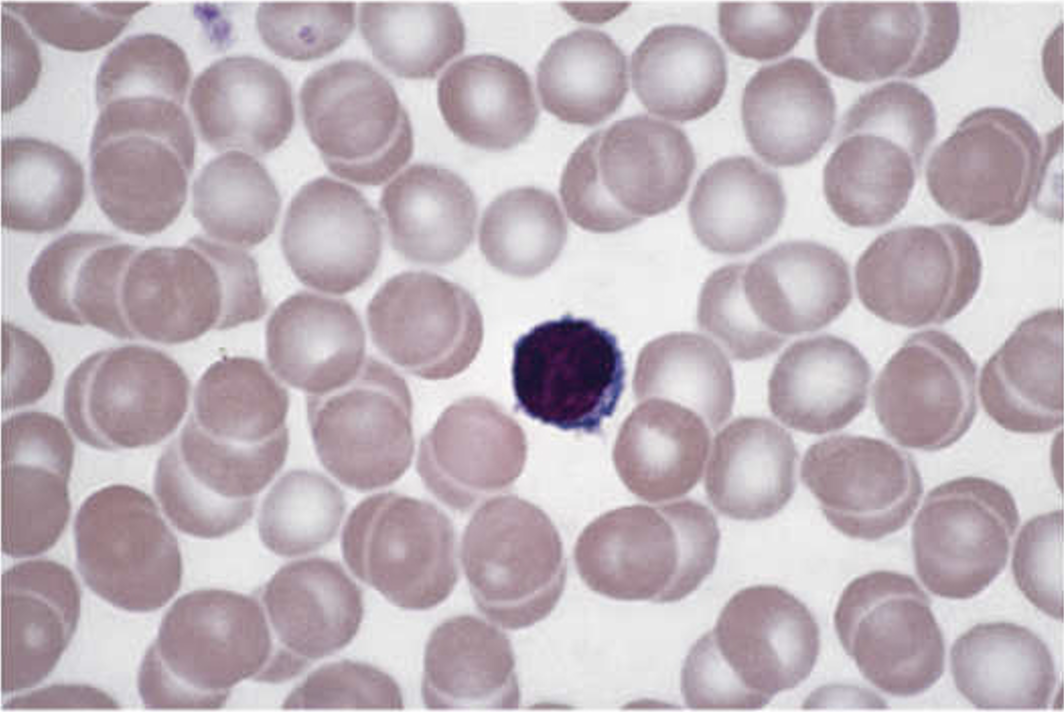
term image

1/174
Looks like no tags are added yet.
Name | Mastery | Learn | Test | Matching | Spaced | Call with Kai |
|---|
No analytics yet
Send a link to your students to track their progress

A
Superior Vena Cava

B
Left Pulmonary Artery

C
Aorta

D
Pulmonary Trunk

E
Left Coronary Artery

F
Right Coronary Artery

G
Circumflex Artery

H
Papillary Muscle

K
Right Ventricle

L
Tricuspid Valve

M
Right Atrium

N
Left Atrium

O
Aortic Semilunar Valve

P
Mitral Valve

Q
Chordae Tendinea

R
Left Ventricle

S
Interventricular Septum

26
Left Atrium

3
Superior Vena Cava

4
Ascending Aorta

5
Arch of the Aorta

6
Brachiocephalic Artery

7
Left Common Carotid Artery

10
Pulmonary Trunk

12
Left Pulmonary Artery

19
Left Pulmonary Veins

20
Inferior Vena Cava

21
Right Atrium

24
Right Ventricle

28
Left Ventricle

34
Apex of Heart

56
Tricuspid Valve

58
Papillary Muscle

59
Chordae Tendinae

63
Pulmonary Semilunar Valve

67
Bicuspid Mitral Valve

70
Aortic Semilunar Valve

73
Sinoatrial Node

74
Atrioventricular Node

75
Bundle of His

A
Superior Vena Cava

B
Right Pulmonary Artery

C
Pulmonary Trunk

D
Right Atrium

E
Right Pulmonary Veins

F
Tricuspid Valve

G
Right Ventricle

H
Chordae Tendineae

I
Inferior Vena Cava

J
Aorta

K
Left Pulmonary Artery

L
Left Atrium

M
Left Pulmonary Veins

N
Mitral (Bicuspid) Valve

O
Aortic Valve

P
Pulmonary Semilunar Valve

Q
Left Ventricle

R
Papillary Muscle

S
Interventricular Septum

Pink Circle
Red Blood Cell
Tiny Circle
Platelet

Circle with Purple Dots
Neutrophil
Eosinophil
Monocyte
Circle on right
Neutrophil
Circle on left
Basophil
Lymphocyte

A
Right Atrium

B
Right Ventricle

C
Auricle of Left Atrium

D
Left Ventricle

E
Right Pulmonary Artery

F
Left Pulmonary Artery

G
Right Coronary Artery

H
Superior Vena Cava

I
Ascending Aorta

J
Pulmonary Trunk

K
Left Pulmonary Veins

L
Right Pulmonary Veins

M
Inferior Vena Cava

12
Trachea

13
Thyroid Gland

14
Left Common Carotid Artery

15
Left Internal Jugular Vein

16
Right External Jugular Vein

17
Left Subclavian Artery

21
Superior Vena Cava

A
Common Iliac

B
Jugular Vein

C
Brachiocephalic

D
Superior Vena Cava

E
Subclavian

F
Cephalic

G
Brachial

H
Axillary

I
Basilic

J
Inferior Vena Cava

K
Renal Vein

L
Superficial Palmar Arc

M
External Iliacs